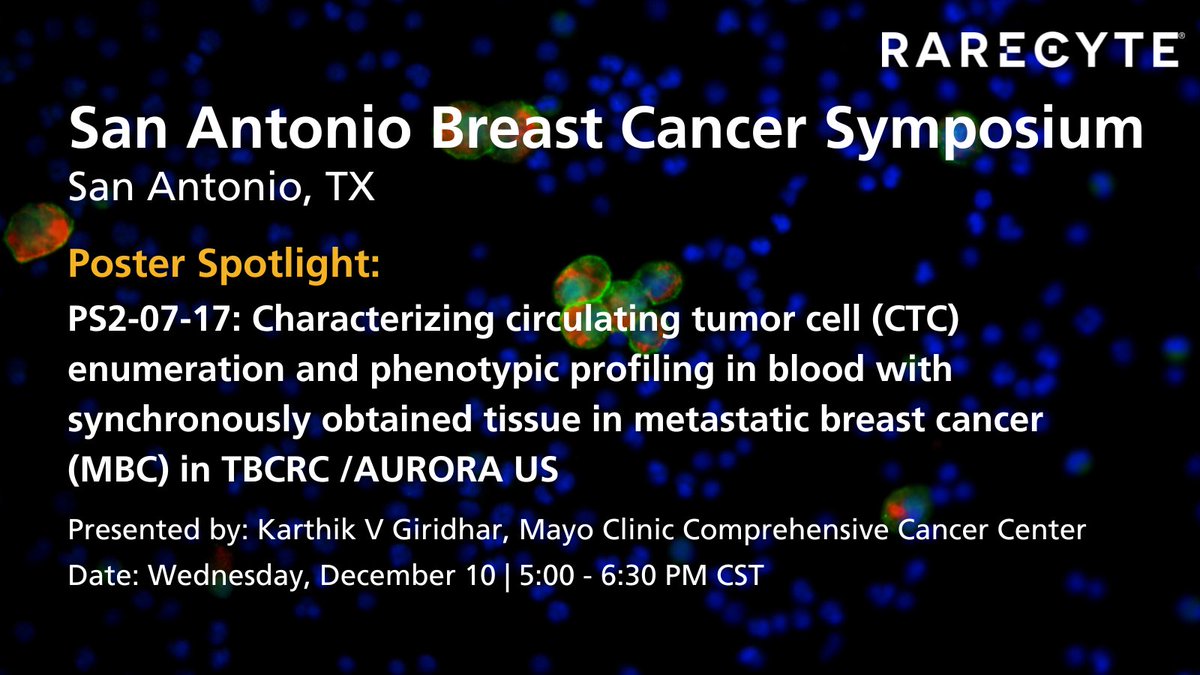
RareCyte, Inc. tweet media

Successful Orion training at @UBC. 🚀 The Poh Lab is using the Orion spatial proteomics platform to map the tumor immune microenvironment in oral cancer.
#SpatialBiology #SpatialProteomics

English
RareCyte, Inc.
943 posts

@RareCyte
Unmatched Clarity in Spatial Biology & Liquid Biopsy








#AACR26 See our work that challenges so many dogmas about #LiquidBiopsies for cancer. ⚫️Not just DNA🧬, CTCs👇🏽 ⚫️Not just blood, CSF🧠 ⚫️Not just prognostic, predictive🎯CDH17 ⚫️Kinetics🟰📉response CSF cytology was negative ➖ So many💡 🔗abstractsonline.com/pp8/#!/21436/p… @OncoAlert

Our next LSW Member Spotlight features @RareCyte! Their technologies are driving major advances in cancer research, immunotherapy development, and next-generation diagnostics by giving scientists insight into rare cells and complex tissue environments. lifesciencewa.org/2025/11/13/mem…





